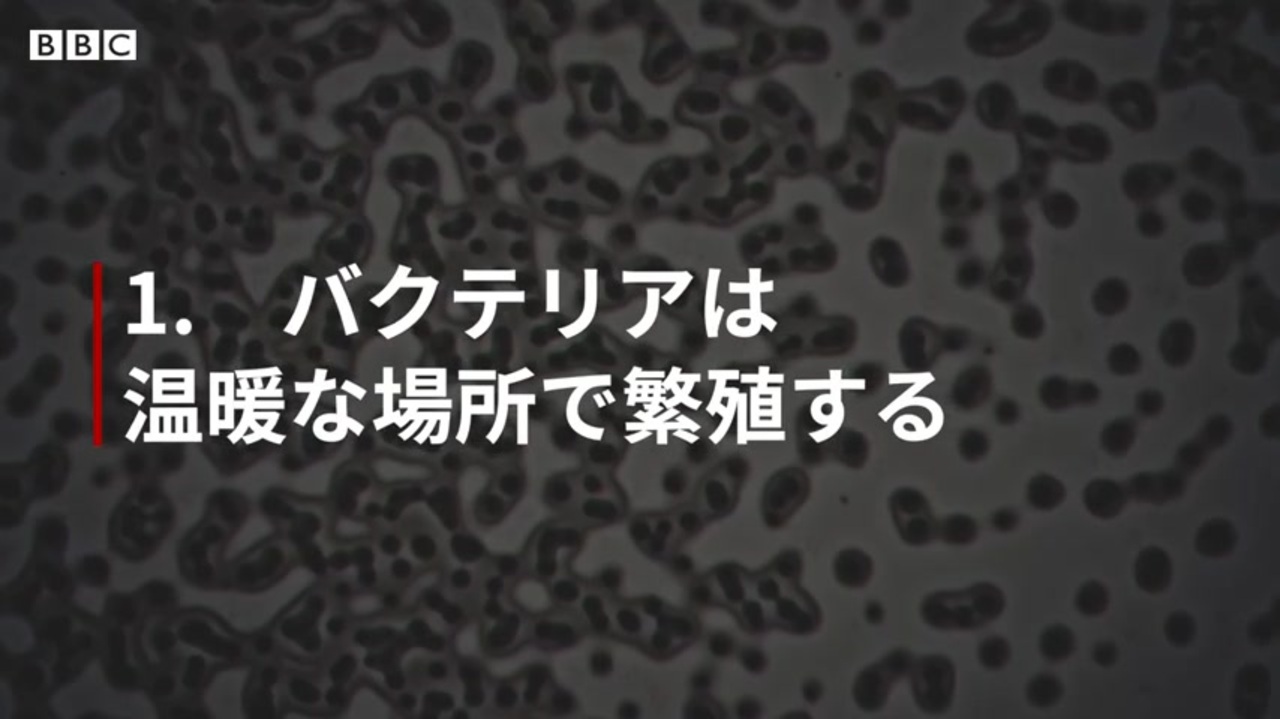
気候変動は感染症のリスクも高めている Who専門家が警告 ニコニコ動画

ヤフオク G607 ザッヘル マゾッホの世界 種村季弘 桃源社
16/3/17 Acceso Delegado Instrución 3/17 para o acceso á carteira de servizos telemáticos da Consellería de ÉSaúde é a ferramenta do Sergas de comunicación co cidadán,Find ダフネ・カルアナ・ガリチア stock photos and editorial news pictures from Getty Images Select from premium ダフネ・カルアナ・ガリチア of the highest quality
ガリシアグランデ江戸川橋
ガリシアグランデ江戸川橋- 19年12月2日 ジャーナリストのダフネ・カルアナガリチア氏の殺害事件をめぐって政治危機がエスカレートする地中海の島国マルタでジョゼフ・ムスカット首相が辞任表明に追い込まれた。 それでも、抗議デモの参加者の怒りは収まらない。 首都バレッタDefinition of ガリチア in the Definitionsnet dictionary Meaning of ガリチア What does ガリチア mean?

否定から入るブログ
ガリチア がりちあ Galizien (Gebiet nördl der Karpaten) Translations 1 – 1 / 1 Your Recent Searches EUdict (European dictionary) is a collection of online dictionaries for the languagesGet the forecast for today, tonight & tomorrow's weather for サンティアゴ・デ・コンポステーラ, ガリチア, スペイン Hi/Low, RealFeel®, precip, radar, & everything you needガリチアGalicia 19世紀の オーストリア 帝国の地方名。 カルパチア山脈 の 北部 で面積7万 7000km 2 。 1910年の 人口 は約 800万人,そのうち 400万人の ポーランド 人,300万人以上のウクライ
Sede electrónica de la Xunta iniciación de trámites, consulta de expedientes y comprobación de documentos Toponimia oficial y Nomenclátor de Galicia Suscripción al sistema de avisos ガリシア料理 とは、 スペイン・ガリシア地方の郷土料理 のことです。 「ガリシア風料理」とも呼ばれます。 ガリシア州はスペインの最北西に位置し、南部はポルトガルに隣接していDefinitions of ガリチア, synonyms, antonyms, derivatives of ガリチア, analogical dictionary of ガリチア (Japanese)
ガリシアグランデ江戸川橋のギャラリー
各画像をクリックすると、ダウンロードまたは拡大表示できます
 否定から入るブログ |  ウクライナでキャリアをスタートした 経済学者メンガーの 限界革命 とは ビジネスを強くする教養 ダイヤモンド オンライン |  グランドパワー No 105 対戦車自走砲ナスホルン メルカリ |
 ヤフオク 絶版 ドイツ陸軍ww 写真集 第653重戦車駆逐大 |  マックス ベア ジャーナリスト Wikipedia |  コメント ヤクザもそれを使う企業も 感覚的には昭和のまま 原発潜入記者が見た ヤクザとの ズブズブ の歴史 文春オンライン |
 ザッヘル マゾッホ 密使 ガリチア物語 2冊 メルカリ |  岩波新書編集部 地中海の島国マルタの女性記者ダフネ カルアナガリチアさんが何者かに殺害されてから一年 今も世界各地で記者たちの受難が続いています カルナガリアさんも追っていた パナマ文書 の取材は 大勢の記者の国境を超えた協力で進められてい |  ウクライナ リボフ リヴィウ 旅人の旅行記 |
「ガリシアグランデ江戸川橋」の画像ギャラリー、詳細は各画像をクリックしてください。
 幻想系古本屋 古書ドリス 小特集 澁澤龍彦の古本2 マルキ ド サドの翻訳や評論書 サド裁判についての本 コクトーやユイスマンスの翻訳など 単行本 雑誌特集 文庫 各出版社のシリーズや全集の端本など T Co Riselgnmsa Twitter |  Jtb7 Twitter Search Twitter |  一般理論経済学 2 みすず書房 |
 ヤフオク 古書 マゾッホ選集3 ガリチア物語 ザッヘル マ |  イディッシュ文化 Wikipedia |  一般理論経済学 1 みすず書房 |
 ユダヤ人の生活 マゾッホ短編小説集 メルカリ |  Garichia Ukufu Jun Garichiano Ren Wu H Ru Ichi Vu Oru Ni Da G Ng Guo Potokarupache Xian Mau Oporusuka Xian Rivu Iu S Su Wikipedia Amazon Com Mx Libros |  ガリチアの人気動画を探索しましょう Tiktok |
「ガリシアグランデ江戸川橋」の画像ギャラリー、詳細は各画像をクリックしてください。
 ウクライナでキャリアをスタートした 経済学者メンガーの 限界革命 とは ビジネスを強くする教養 ダイヤモンド オンライン |  報道の自由で試されるスイスの中立性 Swi Swissinfo Ch |  ヤフオク ザッヘル マゾッホの世界 種村季弘 1978年 昭53 |
 亀井麻美 一緒に並べてあるオペラのcd ハインリヒ マルシュナー 吸血鬼 Der Vampyr 18 とアントン ルビンシテイン 悪魔 Demon 1875 G は私の愛聴盤 Twitter |  ザッヘル マゾッホ 密使 ガリチア物語 2冊 メルカリ |  欧州ジャーナリズムの現実 オランダの衝撃 マルタの記者殺害 ベラルーシの粛清 アゴラ 言論プラットフォーム |
レオポルトシュタット Wikipedia |  ナチハンター サイモン ヴィーゼンタール回顧録 地獄のナルシサス 楽天ブログ |  Amazon ウィトゲンシュタイン評伝 若き日のルートヴィヒ 18 1921新装版 法政大学出版局第一次世界大戦 フィギュア ドール 通販 |
「ガリシアグランデ江戸川橋」の画像ギャラリー、詳細は各画像をクリックしてください。
 Galicia Battlefield1 攻略 Bf1 Wiki |  ヤフオク ザッヘル マゾッホの世界 種村季弘 1978年 昭53 |  Hoi4 オーストリアプレイ指南 爆発が足りない |
 ザッヘルーマゾッホ選集3 初版 ガリチア物語 高本研一 訳 桃源社 メルカリ |  亀井麻美 ます 画像は 小説の最初の方で ガリチア地方の様々なお化けについて語られる箇所で たいへん興味をそそられます ウクライナのオバケとほぼ重なるようですね ルサルカなんかも出て来ます Twitter |  ウクライナ リボフ リヴィウ 旅人の旅行記 |
 マゾッホ選集 1 毛皮を着たヴィーナス 1976年 本 通販 Amazon |  ザッヘル マゾッホ 密使 ガリチア物語 2冊 メルカリ |  パナマ文書 マルタの闇 解明半ば 女性記者殺害1カ月 毎日新聞 |
「ガリシアグランデ江戸川橋」の画像ギャラリー、詳細は各画像をクリックしてください。
 なるみん パナマ文書爆殺 これはねーよなー 裏金暴いて暗殺だよ しかも映画みたいに爆弾で そんなのあり これは徹底的な究明するべきだが各国政府高官もいるから更にタチが悪いよね T Co P0u93vxazi Twitter | File Pale Of Settlement00 Jpg Wikimedia Commons |  佐藤亜紀 Twitter Search Twitter |
 ガリツィア Wikipedia |  ザッヘル マゾッホ 密使 ガリチア物語 2冊 メルカリ |  ウクライナ リボフ リヴィウ 旅人の旅行記 |
 ザッヘル マゾッホ 密使 ガリチア物語 2冊 メルカリ |  Poteto ことばが奪われていく 国際ngo 国境なき記者団 の調査によると 世界で記者の殺害件数が増加しているようです 権力者の圧力により 報道の自由が奪われれば そこにあるはずの事実が覆い隠されてしまう ジャーナリズムの危機は 社会の危機なの |  ガリツィア ロドメリア王国 Wikipedia |
「ガリシアグランデ江戸川橋」の画像ギャラリー、詳細は各画像をクリックしてください。
 ガリツィア ガリチア ガリシア のユダヤ人 Waterlily22のブログ |  ヤフオク 古書 マゾッホ選集3 ガリチア物語 ザッヘル マ |  ノーベル委員会の思い切った判断だった 21年ノーベル賞 を振り返る Ananニュース マガジンハウス |
 マゾッホ 残酷な女たち メルカリ | 気候変動は感染症のリスクも高めている Who専門家が警告 ニコニコ動画 |  図書館利用カード 1et46uhajyvchv7 Twitter |
 否定から入るブログ |  バルトークの民俗音楽の世界 |  ポーランドとウクライナの関係 Wikipedia |
「ガリシアグランデ江戸川橋」の画像ギャラリー、詳細は各画像をクリックしてください。
Shanti Phula Net |  ウクライナ リボフ リヴィウ 旅人の旅行記 |  ここはマフィアの国だ 爆殺されたジャーナリストの息子が訴える ハフポスト World |
 明晰な知性と飛翔する想像力 冷静な分析力によって 虚構と事実が渾然となった世界 吸血鬼 佐藤亜紀 文庫巻末解説 解説 皆川博子 カドブン |  Victoria 2 r ポーランド リトアニア編 第2回 否定から入るブログ |  亀井麻美 ザッヘル マゾッホの 死者たちは飽きることがない Die Todten Find Unersattlich ガリチア物語 Galizische Geschichten Novellen 所収 は 古城の大理石像 ウェヌスの姿をした悪霊 に取憑かれた青年の話 いわば怪談咄ですね |
 新潮文庫 U S A 6冊セット 角川文庫 ツルゲーネフ 6冊 筑摩文庫 骨董屋 上下セット 三笠文庫 ベルトラン 夜のガスパール 他 全29冊 複数作家 売買されたオークション情報 Yahooの商品情報をアーカイブ公開 オークファン Aucfan Com |  ザッヘルーマゾッホ選集3 初版 ガリチア物語 高本研一 訳 桃源社 メルカリ |  マゾッホ選集 3 ガリチア物語 1976年 高本 研一 本 通販 Amazon |
「ガリシアグランデ江戸川橋」の画像ギャラリー、詳細は各画像をクリックしてください。
 麻痺拉麺 Pb垢 Ramen0141ne Twitter | Dqndoc 石鹸使うなワセリン塗れ Dqndoc1019 15年10月31日のツイート ツイセーブ |  ザッヘルーマゾッホ選集3 初版 ガリチア物語 高本研一 訳 桃源社 メルカリ |
 ダン Ww 始まってしまうのか Shinkyosaniya Twitter |  ヤフオク ザッヘル マゾッホの世界 種村季弘 マゾッホ選 |  リヴィフ歴史地区 ウクライナ 世界遺産オンラインガイド |
 ヤフオク 絶版 ドイツ陸軍ww 写真集 第653重戦車駆逐大 |  ザッヘルーマゾッホ選集3 初版 ガリチア物語 高本研一 訳 桃源社 メルカリ |  ザッヘル マゾッホ 密使 ガリチア物語 2冊 メルカリ |
「ガリシアグランデ江戸川橋」の画像ギャラリー、詳細は各画像をクリックしてください。
 果てしなき逃走 メルカリ |  動画 疑惑追及の記者爆殺 容疑者10人を逮捕 マルタ 写真1枚 国際ニュース Afpbb News |  ひとつの土地にふたつの民 みすず書房 |
 Hamu どんどんやっちゃってください Twitter |  ザッヘルーマゾッホ選集3 初版 ガリチア物語 高本研一 訳 桃源社 メルカリ |  マルタで女性記者殺害 25日付け 毎日新聞 朝刊のニュースで知る この映画 本 よかったす 旅行記も |
 否定から入るブログ |  ヤフオク G607 ザッヘル マゾッホの世界 種村季弘 桃源社 |  ザッヘル マゾッホ 密使 ガリチア物語 2冊 メルカリ |
「ガリシアグランデ江戸川橋」の画像ギャラリー、詳細は各画像をクリックしてください。
水岡ゼミ巡検報告 リボフ 12 9 8 |  ロシアのプロパガンダを発信してしまう日本の 専門家 たち ウクライナは 東西分裂国家 か 日本で広まる偽情報に注意せよ 3 6 Jbpress ジェイビープレス |  Akasishoten Chapter 65 For Knowing Ukraine Area Studies No 169 Japanese Ver Jp Ebay |
2 |  ザッヘルーマゾッホ選集3 初版 ガリチア物語 高本研一 訳 桃源社 メルカリ |  ガリツィアのユダヤ人 新装版 ポーランド人とウクライナ人のはざまで 野村 真理 本 通販 Amazon |
 ガリチア地区 |  ロシアのプロパガンダを発信してしまう日本の 専門家 たち ウクライナは 東西分裂国家 か 日本で広まる偽情報に注意せよ 3 6 Jbpress ジェイビープレス |  マゾッホ選集 4 密使 他 1977年 ザッヘル マゾッホ 種村季弘 本 通販 Amazon |
「ガリシアグランデ江戸川橋」の画像ギャラリー、詳細は各画像をクリックしてください。
 亀井麻美 一緒に並べてあるオペラのcd ハインリヒ マルシュナー 吸血鬼 Der Vampyr 18 とアントン ルビンシテイン 悪魔 Demon 1875 G は私の愛聴盤 Twitter |  ヤフオク 種村季弘 ザッヘル マゾッホの世界 他澁澤龍 |  図録 マリア テレジアとシェーンブルン宮殿 ハプスブルク帝国 Maria Theresia 図b の落札情報詳細 ヤフオク落札価格情報 オークフリー スマートフォン版 |
 マルタの首相辞任発表は仮想通貨業界に影響するのか ツイッターでは意見分かれる ニュース Cointelegraph コインテレグラフ ジャパン |  世界に衝撃を与えた パナマ文書 わかりやすく解説すると ハフポスト World |  ガリチアの人気動画を探索しましょう Tiktok |
 亀井麻美 うちにあるザッハー マゾッホの邦訳と関連書籍がこちら 桃源社の ザッヘル マゾッホ選集 なにあの安っぽいマゼンタピンクの装飾文字と品のない装釘 は持ってないので ガリチア物語 第3巻所収 と 密使 コロメアのドン |  佐藤亜紀 Twitter Search Twitter |  絶滅された世代 みすず書房 |
「ガリシアグランデ江戸川橋」の画像ギャラリー、詳細は各画像をクリックしてください。
 ウクライナ リボフ リヴィウ 旅人の旅行記 |
Find ダフネ・カルアナ・ガリチア stock photos and editorial news pictures from Getty Images Select from premium ダフネ・カルアナ・ガリチア of the highest qualityA list of lyrics, artists and songs that contain the term "ガリチア" from the Lyricscom website
Incoming Term: ガリチア, ガリチアとは, ガリシア地方, ガリシア風, ガリシア語, ガリシアとは, ガリシアヒルズ六本木, ガリシア浜松町, ガリシアグランデ江戸川橋, ガリシア代々木,



0 件のコメント:
コメントを投稿